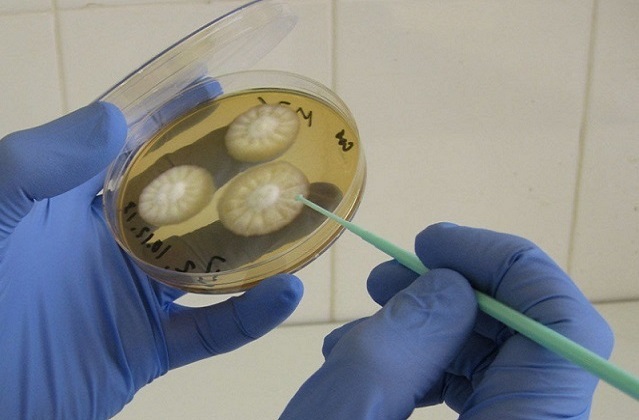
Посев на грибок

Симптоматика заболевания
Кандидоз кожи и ногтей представляет собой коварное заболевание, которое развивается при поражении эпидермиса микроскопическими клетками, связанными между собой так называемыми нитями. Грибковые инфекции развиваются на различных частях тела, но чаще всего местом поражения являются ногти нижних и верхних конечностей.
Кандидоз ногтей сопровождается появлением определенных признаков. Для заболевания характерны следующие симптомы:
- Воспаление. На первичном этапе развития заболевания происходит покраснение кожного покрова вокруг ногтевого ложа. В месте образовавшейся опухоли появляется довольно характерная пульсирующая боль, которая доставляет массу дискомфорта. Если надавить на ногтевой валик, то происходит выделение гноя.
- Прекращение роста ногтей. Воспалительный процесс со временем затихает, боль проходит. Ногтевой валик утолщается, и на кожном покрове образуются небольшие трещинки. Рост ногтевой пластины замедляется или вовсе прекращается.
- Изменение структуры. Следующий этап прогрессирования грибка ногтей сопровождается поражением самой ногтевой платины: меняет цвет, тускнеет и мутнеет. По кроям ноготь может отслаиваться, утолщается и покрывается бороздами. Цвет самой пластины постепенно становится желтовато-коричневым.
Если кандидоз ногтей не лечить, то, спустя некоторое время, происходит отторжение пластины. Ноготь отпадает, что приводит к нарушению эстетических качеств.
Кандидоз ногтей, по мнению врачей, является распространенной грибковой инфекцией, которая может значительно ухудшить качество жизни пациента. Специалисты отмечают, что данное заболевание чаще всего возникает у людей с ослабленным иммунитетом, а также у тех, кто пренебрегает правилами личной гигиены. Врачи подчеркивают важность ранней диагностики и своевременного лечения, так как запущенные формы кандидоза могут привести к серьезным осложнениям, включая потерю ногтя. Лечение обычно включает применение противогрибковых препаратов, как местного, так и системного действия. Кроме того, врачи рекомендуют соблюдать профилактические меры, такие как использование дезинфицирующих средств и ношение удобной обуви, чтобы минимизировать риск повторного заражения.

Особенности заболевания

Кожный покров, пораженный грибковым мицелием, становится красным, истонченным, и блестит. Если надавить на пораженный участок ногтевого валика, то не исключено выделение гноя. Постепенно воспалительный процесс переходит на ноготь, что приводит к изменению его цвета и появлению борозд на пластине. Не исключена вероятность точечного поражения пластины.
Для кандидамикоза характерны коричневые крошащиеся края ногтевой пластины. Заболевание протекает на протяжении длительного времени и имеет несколько периодов обострения.
Классификация
Специалисты выделяют несколько видов грибка кожного покрова:
- Поверхностный. Инфекция поражает только внешние эпителиальные структуры, не проникая глубоко, поэтому легко поддается лечению.
- Генерализованный. Развивается преимущественно в детском и подростковом возрасте. Как правило, имеет хроническое течение.
- Кожно-слизистый. Распространяется на коже вокруг ногтевых пластин, поражая сам ноготь. Быстро переходит на слизистые оболочки.
- Висцеральный. Быстро прогрессирующее заболевание, для которого характерно практически моментальное проникновение грибка внутрь. Часто сопровождается заражением кандидозом внутренних органов.
Чаще всего встречается поверхностная форма кандидоза. Клиническая картина выражена появлением пустул, объединяющихся между собой. Со временем происходит появление небольших эрозий, имеющих багровый окрас. В запущенных случаях происходит образование кандидозных онихий и паронихий.
Кандидоз ногтей — это проблема, с которой сталкиваются многие люди, и мнения о ней весьма разнообразны. Некоторые отмечают, что заболевание проявляется в виде изменения цвета и структуры ногтей, что вызывает дискомфорт и стеснение. Многие делятся опытом лечения, подчеркивая важность своевременной диагностики и обращения к специалисту. Некоторые пациенты отмечают, что народные методы, такие как использование уксуса или эфирных масел, могут помочь в борьбе с грибком, однако врачи предупреждают о необходимости комплексного подхода. Также часто упоминается о том, что профилактика играет ключевую роль: соблюдение гигиенических норм и использование качественной обуви могут значительно снизить риск возникновения кандидоза. В целом, люди стремятся делиться своим опытом и находить эффективные решения для этой неприятной проблемы.

Причины развития
Грибковое заболевание развивается при размножении дрожжеподобной микрофлоры на кожном покрове в области конечностей. Росту грибка способствуют следующие предрасполагающие факторы:
- Снижение защитных сил организма. Длительный прием антибактериальных и гормональных препаратов, инфекционные, вирусные заболевания и гормональные дисфункции снижают иммунитет и подвергают организм воздействию грибкового мицелия.
- Долгий контакт кожи с водой. Размягчение эпителия кожного покрова приводит к снижению местного иммунитета.
- Механические повреждения. Ссадины и трещины в области ногтевого валика способствует проникновению грибковой флоры внутрь.
- Плохая гигиена. Редкое мытье рук и ног, несоблюдение личной гигиены в общественных местах приводит к тому, что грибок проникает в эпителиальные слои и начинает прогрессировать.
В группу риска входят преимущественно женщины в возрасте 30-60 лет. Обусловлено это тем, что представительницы слабого пола, выполняя работу по дому, часто травмируют кожный покров и много контактируют с водой. Также следует выделить профессиональную деятельность, которая увеличивает вероятность инфицирования: официант, строитель, уборщик, сборщик фруктов и банщик. Лица, которые работают в данной сфере, должны больше других соблюдать меры предосторожности. Следует обратить внимание, что грибок ногтей часто поражает людей, болеющих онкологическими заболеваниями и СПИДом. Обусловлено это снижением иммунитета.
К отдельной группе риска относятся дети в возрасте до 16 лет. Они более других подвержены инфицированию грибка, но заболевание у них протекает по-другому. У детей ногтевой валик не воспаляется и ноготь не начинает крошиться, а просто происходит изменение его цвета.
Постановка диагноза
Для дифференцировки диагноза и определения возбудителя имеющихся нарушений в организме возникает необходимость в проведении комплексного обследования. Это помогает отличить грибок ногтей от псориаза, стафилококкового поражения, гормональных дисфункций и сердечно-сосудистых патологий.
Обязательные лабораторные исследования при грибке ногтей:
- ОАК для определения бактериального характера заболевания и исключения аллергической реакции.
- Микроскопическое исследование забора с пораженного участка кожного покрова или пластины. Дает возможность выявить возбудителя заболевания.
- Бактериологическая диагностика. Заключается в проведении посева на питательных средах, что позволяет выявить скорость и тип прорастания грибковой колонии.
Если вовремя не провести диагностику и не начать лечение, то существует большая вероятность развития достаточно серьезных осложнений: распространение грибковой инфекции, переход заболевания в тотальную форму, присоединение бактериальной инфекции. Инфекционное заболевание может перейти в хроническую форму, что чревато появлением рецидивов при воздействии на организм определенных факторов.
Лечебные меры
Лечить кандидоз ногтей следует комплексно. В противном случае результат от принятых мер может быть недостаточно выраженным. Для того чтобы подобрать наиболее эффективные лекарственные противогрибковые препараты, необходимо провести комплексное обследование и выявить форму заболевания и тип возбудителя.
Обратите внимание, что грибковое поражение ногтей достаточно сложно поддается медикаментозной терапии. Именно поэтому нужно как можно раньше начинать лечение, что увеличивает шансы на положительный исход заболевания.
Для того чтобы быстро уничтожить грибок рекомендуется воздействовать местно на очаги инфекции и принимать системные препараты внутрь. Комплексный подход позволяет быстро устранить симптоматику заболевания и подавить эффективность дрожжеподобной микрофлоры, снизив ее количество.
Лекарственная терапия
Локальное лечение инфекционного заболевания проводится с помощью препаратов, которые наносятся местно. Среди наиболее эффективных мер следует выделить использование Алибура и борной кислоты (3% разведения). Эффективными средствами являются спиртовой раствор метил- или генциан виолета. Использовать данные средства следует вместе с препаратами, предназначенными для местного и внутреннего использования. Такой подход к лечению позволяет быстрее справиться с грибковым заболеванием и исключает вероятность развития опасных осложнений.
Наружное лечение грибкового поражения ногтей осуществляется с использованием следующих препаратов:
- «Батрафен». Лекарственный препарат выпускается в форме лака для ногтей. Активное вещество – циклопирокс. Антимикотик широко используется для подавления роста грибкового мицелия путем прекращения поступления в клеточные структуры питательных веществ. Рекомендации по использованию: нанесение на ноготь на протяжении 1 месяца однократно в день. В качестве профилактики, до полного отрастания пораженной грибковой микрофлорой ногтевой пластины. Противогрибковый лак рекомендуется наносить на ногтевую пластину 1 раз в неделю на протяжении полугода.
- «Лоцерил». Противогрибковый лак для ногтей разработан на основе такого активного вещества, как аморолфин. Этот действующий компонент проникает в глубину ногтевой пластины. Рекомендуется использовать 1 раз в день на протяжении 7 суток. После чего делать перерыв на неделю и повторять лечение. Курс терапии составляет от 6 до 12 месяцев.
- «Пимафуцин». Крем, изготовленный на основе натамицина. Препарат быстро снимает симптоматику и лечит грибок ногтя. Наносить следует на пораженные участки кожи 3-4 раза в сутки.
Если эффективность от подобных мер будет недостаточной, то рекомендуется принимать полиеновые системные препараты: «Низорал», «Ламизил» и «Дифлюкан». В обязательном порядке нужно принять меры для коррекции иммунодефицитного состояния, новообразований и заболеваний крови.
При таком заболевании, как молочница ногтей, медикаментозную терапию должен назначать лечащий врач. Самолечение может стать причиной развития осложнений. Чем раньше будут определены симптомы заболевания и приняты лечебные меры, тем больше шансов на полное излечение от грибковой инфекции.

Вопрос-ответ
Каковы основные симптомы кандидоза ногтей?
Симптомы кандидоза ногтей могут включать изменение цвета ногтевой пластины, утолщение или истончение ногтя, а также его ломкость. В некоторых случаях может наблюдаться зуд и воспаление вокруг ногтя.
Как лечится кандидоз ногтей?
Лечение кандидоза ногтей обычно включает использование противогрибковых препаратов, которые могут быть как местными (в виде кремов или лаков), так и системными (в виде таблеток). Важно также соблюдать гигиену и избегать факторов, способствующих развитию инфекции.
Можно ли предотвратить кандидоз ногтей?
Да, профилактика кандидоза ногтей включает поддержание хорошей гигиены, избегание избыточной влаги, ношение удобной обуви и использование дезинфицирующих средств в общественных местах, таких как бассейны и сауны.
Советы
СОВЕТ №1
Регулярно проверяйте состояние своих ногтей и кожи вокруг них. Обратите внимание на изменения цвета, текстуры или появления трещин. Раннее выявление симптомов кандидоза поможет предотвратить его дальнейшее развитие.
СОВЕТ №2
Соблюдайте гигиену ног и рук. Регулярно мойте их с мылом, особенно после посещения общественных мест. Используйте индивидуальные полотенца и избегайте обмена обувью с другими людьми, чтобы снизить риск заражения.
СОВЕТ №3
Укрепляйте иммунную систему. Правильное питание, регулярные физические нагрузки и достаточный сон помогут вашему организму лучше справляться с грибковыми инфекциями, включая кандидоз.
СОВЕТ №4
При первых признаках кандидоза обратитесь к врачу. Специалист сможет назначить правильное лечение и дать рекомендации по уходу за ногтями, что поможет избежать осложнений и рецидивов.